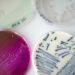
Charité: "Superkeime" als Mitbringsel aus der Ukraine

Der Kiewer Stadtrat hat einen Grundstückspachtvertrag mit der russischen Botschaft gekündigt, teilt Witali Klitschko, Bürgermeister der Hauptstadt, am Donnerstag mit. Die Verwaltung habe ihm zufolge auch an das Ministerkabinett des Landes appelliert, das Eigentum der diplomatischen Mission an den ukrainischen Staat zu übergeben.
Das Botschaftsgelände, das sich in einem zentralen Stadtteil von Kiew befindet, ist seit Februar 2022 geschlossen, als Moskau sein verbliebenes diplomatisches Personal kurz vor Beginn des Krieges aus dem Land evakuierte.
Wladimir Dschabarow, Vizechef des Außenausschusses im russischen Föderationsrat, sagte, Moskau werde wahrscheinlich mit der Beschlagnahme des ukrainischen diplomatischen Eigentums reagieren. “Normalerweise sind die Maßnahmen symmetrisch”, sagte er zur Agentur RIA Nowosti und fügte hinzu, dass die “Ukrainer völlig abtrünnig geworden sind”. Er schloss aber nicht aus, dass das Botschaftsgebäude in Moskau bestehen bleiben könnte, “denn früher oder später werden die Beziehungen wiederhergestellt, und für dieses Regime, das uns gegenüber freundlich gesinnt sein wird, wird das Botschaftsgebäude bereitstehen”.
Ähnlich äußerte sich auch der stellvertretende Sprecher des Föderationsrates, Konstantin Kossatschow: “Dies ist ein Fall, in dem die Reaktion mindestens hundertprozentig spiegelgleich sein sollte. Und die russische Seite hat alle notwendigen Mittel dafür.”
Nach Kriegsbeginn hatte Kiew die diplomatischen Beziehungen zu Moskau abgebrochen. Das russische Außenministerium erklärte damals, dies sei nicht ihre Entscheidung, sondern “das logische Ergebnis der gezielten russophoben Politik der Kiewer Behörden”.
Mehr zum Thema – Australien nimmt Russland Land für den Bau einer Botschaft weg